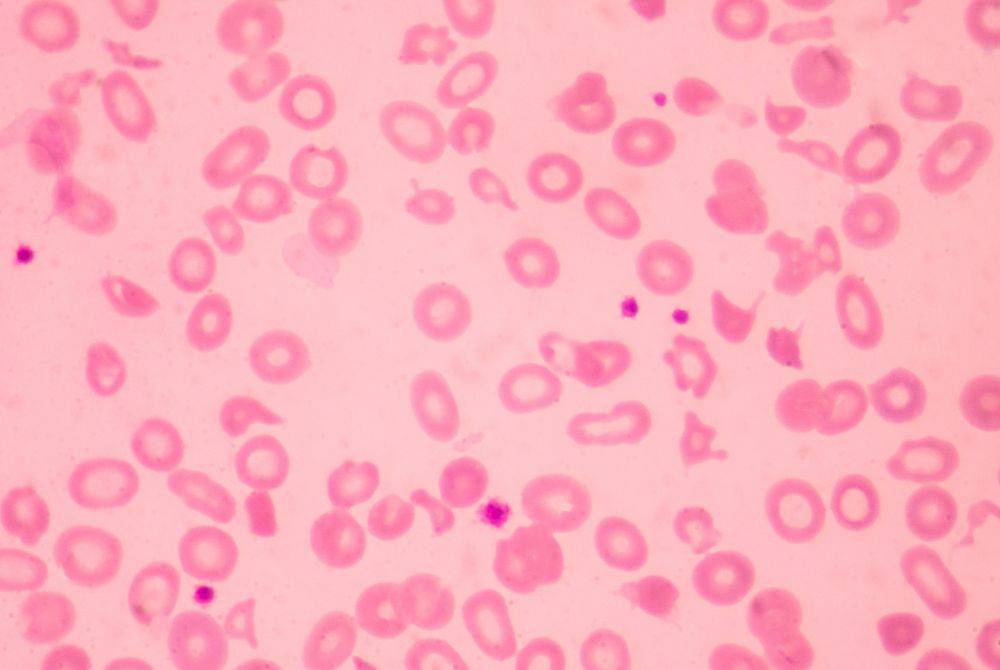
Thalassemia is a hereditary blood disorder that impairs the body’s ability to produce enough haemoglobin, the protein in red blood cells responsible for transporting oxygen, due to a genetic mutation affecting its production. Photo for illustrative purposes only - Canva

Fighting Thalassemia together: Family urges more awareness, less stigma
The emotional toll has been just as heavy as the physical challenges, particularly when witnessing his children’s suffering and fearing for their future.
FOR 30 years, Noorhamidi Ali lived a life free of health issues-until a routine test revealed he was a carrier of thalassemia, a hereditary blood disorder.
The diagnosis came as a shock, made even more emotional when his wife, Noor Hasilah Razak, was also confirmed to be a carrier.
Their journey took a heartbreaking turn in 2006 when their second child, then less than a year old, was found to have thalassemia after suffering from persistent fever.
"At first, the doctor suspected our daughter, Noornafisa Najla, had dengue, but further tests confirmed she was suffering from thalassemia. Following that, the doctor advised my wife, our eldest daughter, and me to undergo screening.
"My wife and I were confirmed as carriers, while our eldest daughter, Noornabila Najwa-then six years old-was diagnosed as a patient,” he told Bernama recently.
In 2008, the couple welcomed their third child, another daughter, who was also found to be a thalassemia carrier.
Now aged 49 and 48 respectively, Noorhamidi and Noor Hasilah have accepted this journey as the will of God.
Despite the challenges, they remain steadfast-though they admit many people still fail to understand the physical and emotional toll thalassemia takes on both patients and carriers.
CHALLENGES
Thalassemia is a hereditary blood disorder that impairs the body’s ability to produce enough haemoglobin, the protein in red blood cells responsible for transporting oxygen, due to a genetic mutation affecting its production.

Sharing his experience, retired firefighter Noorhamidi, who now lives in Gurun, Kedah, said that while carriers often experience milder symptoms compared to patients, he and his wife have faced persistent health issues such as fatigue and frequent dizziness, especially after reaching their 40s.
"Before that, I could handle the physically demanding work of firefighting without any issues. But once I hit 40, I began to feel my strength and stamina declining.
"Both my wife and I now fall sick more easily, experience dizziness and may even faint if we overexert ourselves,” said Noorhamidi, adding that he was unaware of any family history related to the condition.
He added that the emotional toll has been just as heavy as the physical challenges, particularly when witnessing his children’s suffering and fearing for their future.
"The most heartbreaking part is seeing how the disease changes their bodies-bloated stomachs, pale skin. Both Noornabila and Noornafisa struggle to socialise like other children because they tire easily and can’t take part in physically demanding activities,” he shared.
Although both daughters experienced relatively few health issues during childhood, apart from Noornabila, who required a blood transfusion at the age of seven, their conditions began to deteriorate as they reached adulthood.
In January, Noorhamidi opted for early retirement from the Fire and Rescue Department to devote more time to caring for his children.
He now works as an instructor in emergency care, firefighting and fire safety at a private training centre, which offers him greater flexibility to manage his family’s needs.
HOSPITAL - THEIR SECOND HOME
In 2022, doctors confirmed that both daughters had enlarged livers and spleens as well as heart complications that required regular check-ups.
"When they were little, doctors warned us that their liver and spleen could become enlarged because these organs had to work harder than usual.
"In 2022, Noornabila complained of symptoms similar to gastric issues, then shortness of breath and pain on her left side. Tests revealed her spleen had enlarged by eight centimetres.
"Noornafisa also experienced asthma-like symptoms and further examination showed her spleen was also swollen. Doctors decided to proceed with blood transfusions and monitor whether the swelling could be reduced,” he explained.
Now, both daughters require two litres of blood transfusions every two to six weeks, depending on their condition.
"They need two packs of blood-each one litre-during each session. But sometimes there's a shortage, so they receive one pack first and return later for the second,” he said.
At the time, both daughters were still studying-Noornabila at Mara Higher Skills College in Lenggong, Perak, and Noornafisa at Mara Junior Science College in Pendang, Kedah.
"I was then the Fire Station Chief at Yan Fire and Rescue Station. Every time my daughters needed to go to the hospital, I had to fetch them. That became my routine-making hospital trips up to four times a month. It was exhausting, but I accepted it as a test from God,” he said.
Despite the challenges, he is grateful both daughters completed their education. Noornabila now works as a graphic designer, while Noornafisa is continuing her studies at Mara Professional College in Seri Iskandar, Perak.
Every month, Noorhamidi spends at least RM700 on their medical care.
"PLEASE UNDERSTAND OUR SITUATION”
For 25-year-old Noornabila, living with thalassemia is often difficult. She admits that not everyone understands her condition-and some even view her as a burden.
"There were times I felt overwhelmed-worrying about myself, my father having to pay for treatment and the travel costs to and from the hospital. Sometimes, I feel like I’m burdening those around me. I also get uncomfortable questions about marriage.
"I know not everyone understands thalassemia and not everyone is capable of caring for me the way my parents do. I don’t want people to feel like I’m a burden. So please, avoid asking uncomfortable questions," she said.
Grateful to be the daughter of Noorhamidi and Noor Hasilah, she said her father never let her dwell in sadness.
"When I’m down, they lift me up. My parents always tell me not to show weakness. My mum says, this isn’t a curse-it’s a blessing. We must believe in God’s plan," said Noornabila, who is diagnosed with thalassemia major.
She takes 11 deferiprone tablets daily for life and undergoes two litres of blood transfusion every six weeks.
Despite this, she lives life like any other person.
"One week before transfusion, I get tired, pale, and feverish. Back when I was studying, I couldn’t stay up too late-1 or 2 am at most. If I stayed up longer, I’d turn pale and my eyes would go yellow, even with folic acid,” she said.
She expressed gratitude to blood donors for enabling her to continue living and encouraged others fighting chronic illnesses to use their pain as motivation.
"Sickness is not an excuse to fail. We just need to adjust our path according to our condition-but never push ourselves to the point of harming our health,” she added.
STAYING POSITIVE
Living with thalassemia since birth, 19-year-old Noornafisa is currently pursuing a diploma in English Language Communication at Mara Professional College, Seri Iskandar.
She undergoes blood transfusions and follow-up treatments twice a month.
She admitted to feeling nervous during her first transfusion, but now she is used to it.
"Still, every check-up feels like a burden, but I accept it for the sake of my health,” she said, admitting that she occasionally feels down.
Grateful for supportive friends who help during her low points, Noornafisa, like her sister, believes that illness should not be a barrier to success as long as one remains driven.
"I’m motivated to study because I want to prove I can succeed despite my illness. Besides, studying is a form of jihad and a good deed,” she said.
When asked how she manages being sick while away from family, she admitted it's difficult, but she has learned to adapt.
"Thankfully, I rarely fall seriously ill at the dorm. If I feel unwell, I take medicine immediately. And since I live on campus, I can contact the warden or dormmates for help,” she said.
STIGMA
Meanwhile, Noorhamidi said that, like many other diseases, thalassemia patients also face stigma due to their pale skin and bloated stomachs-features that often become the target of ridicule.
In addition, patients face challenges in employment because of frequent medical leave and lower physical endurance compared to healthy individuals.
Drawing from his family’s experience, Noorhamidi hopes the government will increase public awareness of thalassemia through screening programmes and by making thalassemia testing a standard part of secondary school health checks.
"Community centres can also offer counselling, health education, and emotional support. Additionally, subsidies for medication should be expanded to include infusion tools, and special leave should be granted to both patients and their primary caregivers," he said.
Speaking of his hopes for the future, Noorhamidi said as a father, he is often overwhelmed with guilt and fear for his children’s well-being.
"I constantly worry about their future. Will they be able to live normal lives? Will there be someone who can care for them the way my wife and I do?” - BERNAMA
Download Sinar Daily application.Click Here!
